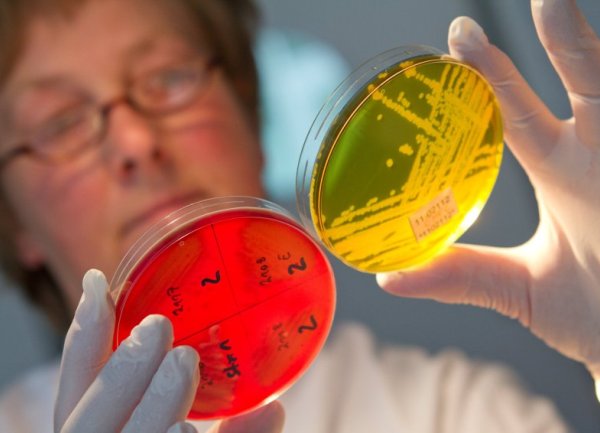
ehec bakterija

U saopštenju se ističe da je moguće da su još neke članice EU i druge evropske zemlje uvozile ili su uvezle sporno sjeme i zatraženo je od Evropske komisije da uloži napor da se spriječi eventualni novi rizik po potrošače.
U saopštenju se ističe da je moguće da su još neke članice EU i druge evropske zemlje uvozile ili su uvezle sporno sjeme i zatraženo je od Evropske komisije da uloži napor da se spriječi eventualni novi rizik po potrošače.
EFSA upozorava da potrošači ne bi trebalo da konzumiraju mladice ili njihovo sjeme ukoliko nisu dobro prokuvani.
Više od 4 100 ljudi u Evropi i Sjevernoj Americi zaraženo kada se bakterija pojavila u dva navrata, i to na sjeveru Njemačke i u okolini francuskog grada Bordoa.
Skoro svi oboljeli u prvom talasu živjeli su u Njemačkoj ili su putovali u tu zemlju. Bakterija je odnijela 48 ljudskih živoata u Njemačkoj i jedan u Švedskoj.
(Nezavisne.com/dg)
PODIJELI NA
Depo.ba pratite putem društvenih mreža Twitter i Facebook
